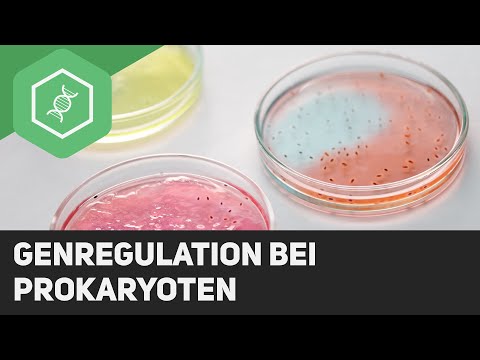
Genregulation bei Prokaryoten

Скачать клипы Genregulation bei Eukaryoten einfach erklärt ↓
![Transcription factors - Enhancers / Silencers [Gene regulation in eukaryotes] - [Biology, advance...](https://img.youtube.com/vi/ni2F06tFWNY/0.jpg)
Transcription factors - Enhancers / Silencers [Gene regulation in eukaryotes] - [Biology, advance...

Epigenetics in 3 minutes - DNA methylation + histone acetylation explained briefly - Biology in a...


![Alternative splicing [gene regulation, eukaryotes] - [Biology, advanced level]](https://img.youtube.com/vi/JsTA_kXVlHY/0.jpg)
![Gene regulation in eukaryotes (transcription and translation level) [Genetics, advanced level]](https://img.youtube.com/vi/C4jJSoESriw/0.jpg)

![DNA-Methylierung + Histonmodifikation [Epigenetische Regulation von Genen] - (Biologie, Oberstufe)](https://img.youtube.com/vi/c6o7Z1qOXcc/0.jpg)



![Lac Operon / Lactose-Operon Modell - Genregulation durch Substratinduktion [1/2]](https://img.youtube.com/vi/-WesQa5ODec/0.jpg)


![RNA interference - mechanism for silencing genes - [Biology, Gene Regulation, Advanced Level]](https://img.youtube.com/vi/znMiF9WKlCM/0.jpg)


